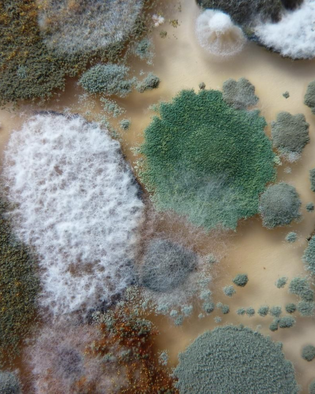

Bei Feuchtigkeit und Schimmelbefall...
Wir sind Ihre Spezialisten für die Ursachen-Ermittlung und für praxisgerechte Problemlösungen z.B. bei:
- Feuchtigkeitsschäden
- Schimmelschäden
- Wasserschäden
- Feuchter Keller
- Balkon / Terrasse defekt
- Hat ein Nutzungsfehler den Schaden verursacht?
- Ist die Bausubstanz verantwortlich?
oder
-
Sie wünschen einen Schimmelpilz-Check
- Sie wünschen vor dem Immobilienkauf/Mietvertrag einen
-
Feuchtigkeits-Check
- Kellerausbau zum Wohnen
- Sie benötigen ein
-
-
unabhängiges Schiedsgutachten
-
gerichtsverwertbares Gutachten
-
maßgeschneidertes Sanierungs-Konzept
-
unabhängiges Schiedsgutachten
... da sind Sie bei uns richtig.

Feuchtigkeitsursachen

Feuchtigkeitsschaden
Warum wir?
Wissen
Über 25 Jahre tiefgreifende Berufspraxis im Bauhandwerk – ergänzt durch fundierte Planung und ingenieurtechnisches Know-how.
qualifiziert
TÜV-geprüfte Ausbildungen und Qualifikationen - nachvollziehbare und rechtssichere Gutachten – fachlich stets auf dem neuesten Stand.
Analyse
Langjährige Erfahrung in der Sanierung von Feuchte- und Schimmelschäden – mit fundierten Analysen und praxisnaher Umsetzung.
seit 2004
Unabhängig, objektiv und technisch modern ausgestattet – mit kontinuierlicher Weiterbildung und hochwertiger Messtechnik.
Unser Service auf einen Blick

FEUCHTIGKEITSSCHÄDEN
Die präzise Ermittlung der Feuchtigkeitsursachen mit unserem spezialisierten Fachwissen und modernster Messtechnik ist die Grundlage für unsere maßgeschneiderten Sanierungskonzepte und für nachhaltige Sanierungen.
Unser vordringliches Ziel bei der Begutachtung von Feuchtigkeitsschäden ist zunächst die vollständige Ergründung aller Feuchtigkeits-Ursachen. Unabhängig davon geben wir Empfehlungen für Sofortmaßnahmen zur Schadensminimierung und zur Gesundheitsvorsorge. Wenn die Ursachen ergründet sind, folgen anschließend unsere Sanierungsempfehlungen. Häufig enthält unser Sanierungskonzept auch alternative Lösungen oder kostenmäßig günstigere Kompromiss-Lösungen je nach Nutzungs-Art der betroffenen Gebäude-Bereiche.
SCHIMMELSCHÄDEN
Fachgerechte Analyse, gesunde Lösungen – für nachhaltige Sanierungen.
Schimmel in Wohn- oder Arbeitsräumen ist nicht nur ein optisches oder geruchliches Problem – er kann ernsthafte gesundheitliche Folgen haben. Besonders Menschen mit Allergien, Asthma oder einem geschwächten Immunsystem reagieren oft sensibel auf Schimmelsporen und deren Gifte.
Wir bieten Ihnen eine fundierte Analyse und individuelle Sanierungskonzepte auf Basis modernster Messtechnik, mikrobiologischer Laboruntersuchungen und langjähriger Erfahrung. Dabei steht für uns an erster Stelle: die genaue Ursachenermittlung – denn nur so lassen sich Schimmelprobleme dauerhaft und sinnvoll lösen. Zusätzlich geben wir klare Empfehlungen für Sofortmaßnahmen zur Schadensbegrenzung und Gesundheitsvorsorge.
Ob sichtbarer Befall, versteckter Schimmel oder wiederkehrende Feuchte – wir beraten Sie kompetent und transparent.

WASSERSCHÄDEN
Schnell erkannt. Fachgerecht gehandelt. Dauerhaft gelöst.
Wasserschäden zählen zu den häufigsten Ursachen für teure Bauschäden – ob durch Rohrbrüche, undichte Leitungen oder Überschwemmungen. Unser Spezialgebiet ist die fachkundige Begutachtung solcher Schäden – mit technischem, physikalischem und mikrobiologischem Know-how.
Anders als schleichende Feuchtigkeitsschäden, entstehen Wasserschäden meist plötzlich und erfordern eine schnelle Reaktion. Wird das Wasser rechtzeitig gestoppt und die betroffenen Bereiche professionell getrocknet, lassen sich Folgeschäden deutlich minimieren. Wir stehen Ihnen mit langjähriger Erfahrung, modernster Technik und klaren Handlungsempfehlungen zur Seite – transparent, unabhängig und lösungsorientiert.

FEUCHTER KELLER
Ursachen erkennen. Schäden vermeiden. Werterhalt sichern.
Ein feuchter Keller ist nicht nur unangenehm, sondern kann langfristig zu erheblichen Bauschäden führen. Die Ursachen sind vielfältig – von Kondenswasserbildung an kalten Wänden bis hin zu eindringender Feuchtigkeit aus dem Erdreich.
Mit modernster Messtechnik und über 25 Jahren Erfahrung analysieren wir präzise die Feuchtigkeitsursachen und erstellen individuelle Sanierungskonzepte. Dabei berücksichtigen wir auch salzhaltige Belastungen im Mauerwerk, die Oberflächenschäden und Schimmelbildung begünstigen können.
Unsere professionelle Bauzustandsanalyse bildet die Grundlage für nachhaltige, wirtschaftlich sinnvolle Lösungen – damit Ihr Keller dauerhaft trocken bleibt.

HEIZ-/LÜFTUNGSANALYSEN
Wenn Schimmel zum Streitfall wird – liefern wir die Fakten.
Bei Schimmel in Mietwohnungen stellt sich oft die Frage: liegt es am Bau – oder am Nutzungsverhalten? Mit präziser Messtechnik und jahrelanger Erfahrung analysieren wir Heiz- und Lüftungsverhalten objektiv und nachvollziehbar.
Durch Raumklima-Messungen, Befragungen und mehrtägige Datenaufzeichnungen ermitteln wir, ob ausreichend gelüftet und geheizt wurde – oder bauliche Mängel vorliegen. Unsere Analysen helfen bei der sachlichen Klärung und liefern fundierte Empfehlungen – für Eigentümer, Mieter oder Verwalter.
Ob als Konfliktlösung oder Präventionsmaßnahme: Wir bringen Transparenz in die Diskussion.

WÄRMESCHUTZ-PRÜFUNGEN
Schimmel trotz Lüften? Wir prüfen den baulichen Wärmeschutz.
Wenn bei Schimmel kein Feuchteschaden vorliegt und korrektes Lüften vermutet wird, liegt der Verdacht auf baulichen Schwächen – etwa in Form von unzulässigen Wärmebrücken in Außenwandecken.
Wir führen mehrtägige Temperaturmessungen im Innen- und Außenbereich durch, um zu prüfen, ob der vorgeschriebene Mindestwärmeschutz gemäß DIN 4108 eingehalten wird. Die Ergebnisse zeigen, ob die Wand zu kalt wird – und somit Schimmel auch bei korrektem Heiz- und Lüftungsverhalten entstehen kann.
Unsere Messungen liefern klare Fakten – als Grundlage für fundierte Entscheidungen und nachhaltige Lösungen.

MESSTECHNIKEN
Präzise Messungen für klare Entscheidungen.
Zur Ursachenanalyse von Feuchte-, Schimmel- oder Bauschäden setzen wir moderne, bewährte Messmethoden ein – je nach Bedarf und Schaden individuell ausgewählt.
Ob zerstörungsfreie Feuchtemessung, elektrische Widerstandsmessung oder präzise Laboranalysen durch DARR-Trocknung und Schadsalz-Analysen – wir liefern exakte Daten statt Vermutungen. Das schafft Klarheit bei Sanierungsentscheidungen, Streitfragen und Planungen.
Unsere technische Ausstattung ist vielseitig – unser Know-how ist Ihre Sicherheit.
Das sagen unsere Kundinnen und Kunden ...
Der Mieter unserer Wohnung hatte Schimmelbildung in der Ecke im Schlafzimmer beanstandet und die Miete gekürzt. Er behauptete, die Mauer sei dort von außen feucht. Herr Tischer stellte durch Messungen fest, dass die Mauer in der Tiefe trocken war und der Schimmel deshalb im Winter durch Innenkondensation verursacht worden sein muss. Im anschließenden Winter führte Herr Tischer deshalb mehrtägige Reihenmessungen mit aufzeichnenden Messgeräten durch. Dabei stellte er fest, dass die Wärmedämmung der Mauer in der Ecke zu schwach ist. Die Diagnose war, dass der bauliche Mindestwärmeschutz zur Schimmelvermeidung dort nicht erfüllt ist. Allerdings kam bei den Messungen auch heraus, dass zeitweise die Raumluft während der Messungen zu feucht war und ebenfalls das Schimmelrisiko erhöhte. Zur Problembeseitigung befolgten wir Herrn Tischers Empfehlungen und ließen im Schlafzimmer eine kapillaraktive Dämmung anbringen. Außerdem stellten wir dem Mieter gemäß Herrn Tischers Empfehlung ein spezielles Wohnraum-Hygrometer mit Alarmfunktion zur Verfügung, so das er sein Lüftungsverhalten verbessern konnte. Im letzten Winter gab es nun keinen Schimmelschaden mehr. Wir schätzten Herrn Tischers angenehmes, kompetentes Auftreten und auch sein Geschick zur Entspannung des Verhältnisses mit unserem Mieter.
Martin M. (Schimmelbefall)
Super kann ich nur weiter empfehlen. Schneller Termin und gute Beratung.
Eymen
In unserer Penthouse-Wohnung waren Feuchtigkeits- und Schimmelschäden an den Wandsockeln aufgetreten. Auf Empfehlung unserer Versicherung beauftragten wir den Sachverständigen Herrn Tischer mit der Begutachtung. Er ermittelte als Ursache eine Undichtigkeit an einem Abwasserrohr. Das Leckwasser hatte sich offenbar über längere Zeit bereits unbemerkt im Bodenaufbau in die angrenzenden Räume ausgebreitet und einen beträchtlichen Wasserschaden erzeugt. Wegen der langen Einwirkzeit des Leckwassers stellte der Sachverständige den Verdacht fest, dass im Bodenaufbau mit einem gesundheitsrelevanten Schimmelbefall zu rechnen sei. Deshalb entnahm er Materialproben aus dem Bodenaufbau und ließ diese im Labor mikrobiologisch auf Schimmelpilze untersuchen. Die Schimmelbefunde im Bodenaufbau waren so bedenklich hoch, dass Herr Tischer letztlich gemäß den fachlichen Richtlinien für Schimmelsanierungen den Austausch des gesamten Bodenaufbaus einschließlich Fußbodenheizung empfehlen musste. Die umfangreihen Sanierungsmaßnahmen inklusive Schimmelentfernung erfolgten dann gemäß den detaillierten Einzelempfehlungen in Herrn Tischers Gutachten. Nach der Schimmelsanierung führte Herr Tischer die Sanierungskontrolle mittels mikrobiologischer Freimessung durch. Wir waren rundum mit Herrn Tischers fachkundigem und symphatischem Wirken sehr zufrieden.
Rita Tauscher (Wasserschaden)
Volle Empfehlung! Das Geld für nutzlose, teure Injektionen können wir uns jetzt sparen. Die Ursache für die feuchte Wand ist nämlich nur Kondensation und ein Luftentfeuchter löst jetzt das Problem im Keller-Hobbyraum.
Horst (Feuchte Wand und Schimmel im Hobbyraum)
Ich bin äußerst zufrieden mit der Arbeit von Herrn Sachverständigen Tischer. Nachdem für unseren langjährig feuchten Keller bereits verschiedene Sanierungsfirmen unterschiedliche und z.T. widersprüchliche Ursachen und Sanierungsmethoden benannt hatten, beauftragten wir nun Herrn Tischer mit der Begutachtung. Durch gründliche Messungen, Maueruntersuchungen und Öffnungen an Bauteilen ermittelte er drei, sich überlagernde Feuchtigkeitsursachen. Im Gutachten erläuterte er die Ursachen verständlich und gab Empfehlungen für Abdichtungs-Maßnahmen und zur Bekämpfung von Kondensationsfeuchte. Dabei stellte er auch Alternativen für Abdichtungsmaßnahmen von Außen oder von Innen dar. Wir werden nun Sanierungsangebote von Fachfirmen gemäß den Einzelmaßnahmen im Gutachten einholen.
H. Klöpfel (Feuchter Keller)
Ich hatte Herrn Tischer gebeten, den Keller des angebotenen Hauses auf Feuchtigkeitsprobleme zu beurteilen. Er stellte zwei Schwachpunkte bei der Kellerabdichtung fest, die der Makler nicht erwähnt hatte. Ich konnte daraufhin eine Kaufpreisminderung durchsetzen, die noch unter den Kosten der inzwischen erfolgten Abdichtungsmaßnahmen lag.
F. Schmid (Immobilienkauf)
Danke, Herr Tischer, wir haben jetzt eine Sanierungsfirma mit den Arbeiten gemäß Ihren Empfehlungen beauftragt. Ihre Beratung hat uns die unnötigen Kosten für die überzogenen, bisher angebotenen Arbeiten erspart.
K. Herrmann (Balkonschäden)
Häufig gestellte Fragen...
Was kostet ein Gutachten?
Das Honorar bemisst sich vorwiegend nach dem Zeitaufwand gemäß dem aktuellen Stundensatz. Nach Ihrer Anfrage sende ich Ihnen ein entsprechendes Angebot per Email.
Eine Begutachtung mit Feuchtigkeitsmessungen im Raum München mit mündlicher Ergebnismitteilung und Maßnahmenempfehlungen kostet aktuell ab ca. € 300.- + MwSt.
Eine komplexere Begutachtung z.B. für feuchte Wände, feuchter Keller oder für Wasserschaden bzw. Feuchteschäden mit schriftlichem Gutachten erfordert mehr Aufwand.
Wie schnell erhalte ich einen Ortstermin?
Je nach aktueller Auslastung kann ich Ortstermine meist innerhalb von ein bis drei Wochen anbieten.
Bieten Sie auch mündliche Gutachten an?
Ja, Sie können beim Ortstermin entscheiden, ob Ihnen eine mündliche Mitteilung der Begutachtungsergebnisse und der Maßnahmen-Empfehlungen ausreicht oder ob Sie eine schriftliche Ausarbeitung wünschen.
Wie lange dauert es vom Ortstermin bis zum Erhalt des Gutachtens?
Je nach Auslastung und Komplexität erhalten Sie mein Gutachten meist innerhalb von zwei bis vier Wochen.
Sind Ihre Gutachten gerichtsverwertbar?
Ja, alle meine schriftlichen Ausarbeitungen entsprechen den Grundsätzen für qualifiziert nachvollziehbare Gutachten.
Bezahlt meine Versicherung Ihr Honorar?
Ich empfehle Ihnen, mein Angebot vor Auftragserteilung Ihrer Versicherung vorzulegen.
Enthält Ihr Gutachten auch ein Sanierungskonzept?
Ja, jedes Gutachten endet mit den Maßnahmenempfehlungen.
Beseitigen Sie auch Schimmelschäden?
Nein, als Sachverständiger für Feuchtigkeitsschäden und Schimmelschäden und Gutachter für Feuchteschäden und für Wasserschäden führe ich Feuchtigkeitsmessungen durch, ergründe die Schadensursachen und erteile die Maßnahmen-Empfehlungen zur fachgerechten Schadensbeseitigung oder Kellersanierung und zur nachhaltigen Vermeidung erneuter Schäden. Ich bin überwiegend im Raum München tätig.
Muss der Mieter das Schimmel-Gutachten bezahlen, wenn er falsch gelüftet hat?
Richten Sie diese juristische Frage bitte an Ihren Rechtsberater. Die Frage geht über meine Zuständigkeit als technischer Gutachter für Feuchtigkeitsschäden, Schimmelbefall und Gutachter für Wasserschaden hinaus.
Sachverständigenbüro Dipl.-Ing. (FH) Tischer
Feuchtigkeitsschäden und Schimmel-Schäden an Gebäuden
Bavariastr. 1, 80336 München
Tel. 089-6223 2755
Fax 089 6223 2756
Email: sv5@ svti.de
